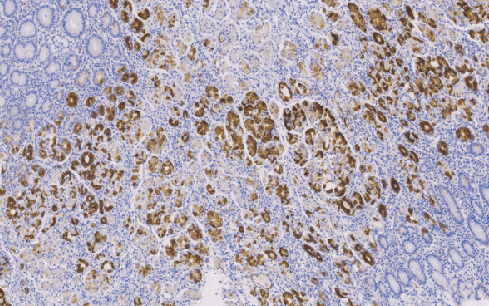
产品细节图片1
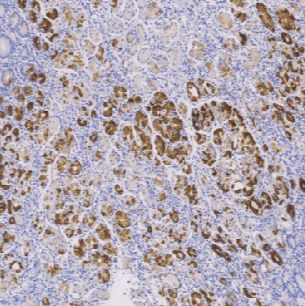
产品封面图

相关产品推荐更多 >
万千商家帮你免费找货
0 人在求购买到急需产品
- 详细信息
- 文献和实验
- 技术资料
- 免疫原:
Recombinant human AMACR protein:full length
- 亚型:
lgG
- 形态:
Liquit
- 保存条件:
-20℃
- 克隆性:
单克隆
- 标记物:
详询
- 适应物种:
Human,(predicted:Mouse,Rat,)
- 保质期:
1年
- 抗原来源:
peptiede
- 目录编号:
TDCMM-0290
- 级别:
科研级
- 库存:
88
- 供应商:
武汉天德
- 宿主:
鼠
- 应用范围:
WB=1:500-1000
- 浓度:
1mg/ml
- 靶点:
详询
- 抗体英文名:
MuCIn-6 Glycoprotein
- 抗体名:
MuCIn-6 Glycoprotein
- 规格:
1ml工作液
Mucin-6Glycoprotein鼠抗人粘液素糖蛋白6单克隆抗体
粘蛋白是一组高分子量的糖蛋白,其合成和分泌是腺上皮组织的特征之一。在生理状态下Muc-2只表达于正常肠粘膜中,又称肠型粘液;Muc-5AC和Muc-6只在正常胃粘膜中表达,又称为胃型黏液。在胃肠道肿瘤的鉴别诊断中,三者联合应用有一定的意义。
- 货号:TDCMM-0290
- 克隆号:MRQ-20
- 阳性部位:胞质
- 适用组织:石蜡切片
- 预处理:热修复
风险提示:丁香通仅作为第三方平台,为商家信息发布提供平台空间。用户咨询产品时请注意保护个人信息及财产安全,合理判断,谨慎选购商品,商家和用户对交易行为负责。对于医疗器械类产品,请先查证核实企业经营资质和医疗器械产品注册证情况。
文献和实验试验。 (四)单克隆抗体胶体金试验 免疫胶体金法是将羊抗人HCG抗血清(多抗)、羊鼠IGG分别固定特制的纤维素试带上并呈两条线上下排列,羊抗鼠IGG线在试带知上方为阴性对照,羊抗人HCG多抗在下方为测定。试带条中含均匀分布的胶体金标记鼠抗人β-HCG单克隆抗体和无关的金标记鼠IGG.检测时将试带浸入被检尿液中(液面低于固定的两条抗体线)后迅速取出。尿液沿试带上行,尿中的β-HCG在上行过程中与胶体金标记单克隆抗体结合,待行至羊抗人HCG抗体线时,形成金标记的β-HCG单元抗尿HCG羊抗人HCG
是一种广谱的标记物。经实验证明,它对胃癌,肠癌,肺癌,乳腺癌,胰腺癌,子宫颈癌,子宫体腺癌,卵巢癌,皮肤鳞状细胞癌,膀胱移行上皮癌,食道癌等,抗原表达阳性,在上述的同类组织及癌旁类性组织,也可见到阳性物,有文献报导,用CEA标记滑膜内瘤,间皮瘤,上皮样内瘤和脑膜瘤,也可表达阳性。 目前,CEA有两种产品,一是单克隆抗体,另一是多克隆抗体。 ① 单克隆小鼠抗 人CEA,克隆为A5B7。 该抗体的特点,纯度高,杂质含量少,很少引起非特异性染色,同时,也不与含糖蛋白
酸和天冬氨酸以外的任意一种氨基酸)N--糖基化序列的特异天冬酰胺残基上开始,当新合成的蛋白质进入内质网腔后就发生 N 端序列糖基化反应(图 25-1B )。接着,当糖蛋白从内质网经高尔基体到达其最终目的地时,Glc3Man9GlcNAC2 前体沿着分泌途径进行进一步加工处理。如果糖基侧链能被内质网和高尔基体中的糖苷酶和糖基转移酶加工的话,Glc3Man9GlcNAc2 前体就会被成功转化为 Man9GlcNAc2 和 Man5GlcNAC2 范围内的髙甘露糖型 N-聚糖(图 25-1A), 以及复杂
技术资料暂无技术资料 索取技术资料